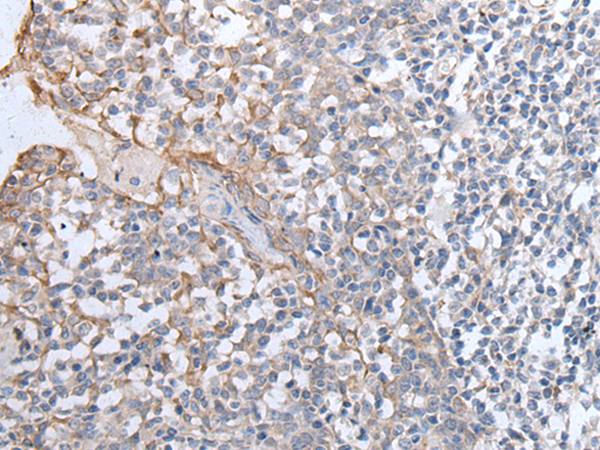

|
Background: |
The protein encoded by this gene localizes to the inner mitochondrial membrane and catalyzes the conversion of glycerol-3-phosphate to dihydroxyacetone phosphate, using FAD as a cofactor. Along with GDP1, the encoded protein constitutes the glycerol phosphate shuttle, which reoxidizes NADH formed during glycolysis. Two transcript variants encoding the same protein have been found for this gene. |
|
Applications: |
ELISA, IHC |
|
Name of antibody: |
GPD2 |
|
Immunogen: |
Synthetic peptide of human GPD2 |
|
Full name: |
glycerol-3-phosphate dehydrogenase 2 |
|
Synonyms: |
GDH2; GPDM; mGPDH |
|
SwissProt: |
P43304 |
|
ELISA Recommended dilution: |
2000-5000 |
|
IHC positive control: |
Human tonsil |
|
IHC Recommend dilution: |
30-150 |
購(gòu)物車(chē)
幫助
021-54845833/15800441009
